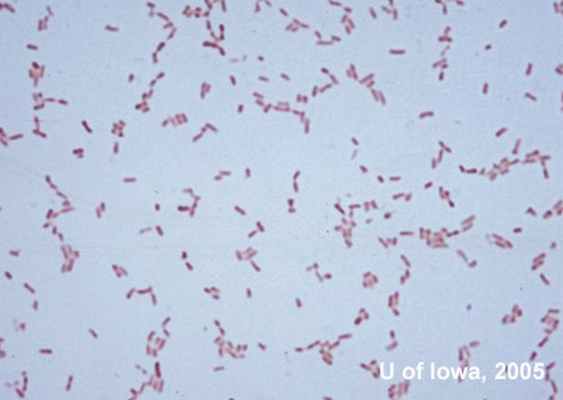
image
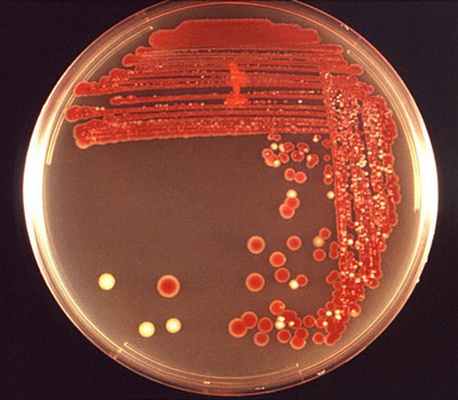
image
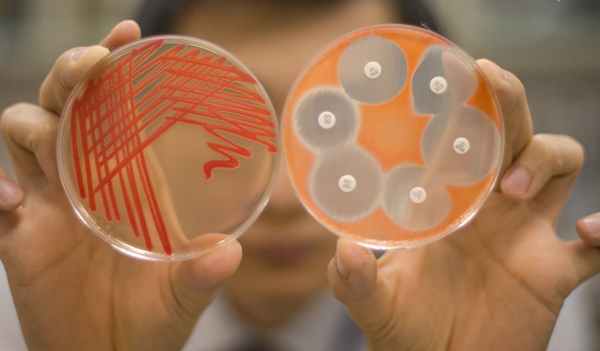
image

Серрации. Serratia marcescens. Свойства серраций. Эпидемиология серраций. Распространенность серраций.
Добавил пользователь Alex Обновлено: 02.11.2025
Род Serratia – таксон семейства Энтеробактерий. Род состоит из 11 видов. Типовой вид – Serratia marcescens. Название рода свяано с именем лоцмана Серафино Соррати. Факторы патогенности бактерий рода Serratia изучены недостаточно. Установлено, что отдельные виды рода являются непосредственными участниками патокомплекса корнееда свеклы [1] [2] .
Виды - представители рода Serratia
Морфология
Для типового видаSerratia marcescens характерен синтез продигиозина – ярко-красного пигмента, по цвету сходного с человеческой кровью. «Евхаристийское Чудо» (появление на хлебе, предназначенном для причастия прихожан, красных пятен), произошедшее в 1263 году в городе Больсен (Италия) объясняют заселением хлеба этим видом бактерий. Из-за этого Serratia marcescens называют «палочкой чудесной крови» или «чудесной палочкой» [2] .
Биология
Бактерии рода Serratia ферментируют глюкозу и другие углеводороды с образованием кислоты и газа. Из триптофана образуют индол (исключение – некоторые штаммы Serratia adorifera). Кроме того, они дают положительную реакцию Фогеса – Проскауэра (исключение – вид Serratia fonticola), образуют лизиндекарбоксилазу и орнитиндекарбоксилазу, но не способны синтезировать аргининдегидролазу. Серрации не выделяют сероводород, не способны утилизировать малонат, восстанавливают нитраты.Температурный оптимум роста +25°C–+30°C [2] .
Распространение
Род Serratia – распространен повсеместно в окружающей среде. Представители рода могут быть выделены из почвы, воздуха, воды, различных растений, испражнений насекомых и грызунов [2] .
Медицинское и ветеринарное значение
Виды рода Serratia, особенно типовой, долгое время не относили к разряду патогенных. Позднее, в 60-е годы XX века, была доказана их способность вызывать бактериемии у наркоманов и пациентов стационарных отделений. Выяснилось, что у детей серрации чаще колонизируют желудочно-кишечный тракт, а у взрослых – мочевыводящие и воздухоносные пути [2] .
В настоящее время установлено, что вид Serratia marcescens вызывает до 10% случаев госпитальных пневмоний и бактериемий, 5% инфекций мочевыводящих путей, гнойничковых поражений кожи и хирургических ран [2] .
Один из самых важных моментов – способность серраций к горизонтальной передаче через руки медицинского персонала. Чаще всего представители данного рода проникают в организм человека через постоянные катетеры, через препараты и растворы для внутривенных вливаний [2] .
Стоит отметить, что у наркоманов, принимающих наркотические препараты внутривенно, часто наблюдаются септические артриты, остеомиелиты и эндокардиты [2] .
В ветеринарии установлены факты заболевания коров маститом и другие инфекции животных, вызванные жизнедеятельностью бактерий рода Serratia [2] .
Болезни сх. культур , вызванные
Serratia
Сельскохозяйственное значение
Род Serratia – включает несколько фитопатогенных видов. В частности, Serratia corallina (Hefferan) Bergey, Serratiabetae Sturzeret Wsorow, являются участниками патокомплекса корнееда сахарной свеклы [3] [1] .
Описание исследования
Serratia species (серрации) – это имеющие форму палочек грамотрицательные условно-патогенные бактерии семейства Enterobacteriaceae. Они являются факультативными анаэробами*, отличаются подвижностью и широким распространением в окружающей среде. Значительное количество серраций содержится в человеческом кале. Наиболее распространенным и изученным видом Serratia species является Serratia marcescens. Виды S. plymuthica, S. liquefaciens, S. rubidaea и S. odoriferae более редкие.
Проведенные исследования показали, что все перечисленные виды Serratia species являются возбудителями различных инфекций в организме человека. Заражению серрациями чаще всего подвержены лица с ослабленным иммунитетом, наркоманы. Однако особую группу риска составляют пациенты стационаров, особенно перенесшие хирургические операции (90% случаев инфицирования урогенитального тракта Serratia species приходится именно на послеоперационных больных). По статистике в 10% случаев заражения внутрибольничными инфекциями именно серрация становится причиной развития воспаления легких, 5% - инфицирования уретры и хирургических ран.
Заражение Serratia species происходит:
- передачей через руки от инфицированного лица здоровому (в т. ч. от медперсонала к пациентам);
- при использовании постоянных катетеров и интубационных трубок (как правило, они применяются для осуществления искусственной вентиляции легких, реанимационных мероприятий);
- при введении в вену лекарственных препаратов и растворов.
Serratia species являются возбудителем:
- заболеваний дыхательных путей (особенно после процедур вентиляции бронхов и легких);
- менингита (воспаления оболочек головного и спинного мозга) и абсцесса мозга (скопления гноя) – у недоношенных детей, взрослых после нейрохирургических операций и эпидуральных инъекций (местного обезболивания путем введения через катетер лекарственных средств в пространство между твердой оболочкой спинного мозга и надкостницей позвонков);
- остеомиелита (поражения костной ткани);
- артрита (воспаления суставов);
- эндокардита (воспаления внутренней оболочки сердца);
- паротита (воспаления околоушной железы);
- бактериального кератита (воспаления роговицы глаза).
У взрослых пациентов серрации обычно поражают мочевыводящие пути и органы дыхательной системы. У детей бактерия является возбудителем желудочно-кишечных инфекций. У наркозависимых лиц результатом инфицирования чаще всего становится развитие септических артритов (при данном заболевании суставы опухают и болят, становятся горячими и малоподвижными), эндокардита, остеомиелита.
Поскольку Serratia species проявляют резистентность (устойчивость) ко многим антибактериальным препаратам, то в случае их выявления и перед определением тактики лечения пациенту рекомендуется пройти обследование на индивидуальную чувствительность к антибиотикам.
Данное обследование проводится методом полимеразной цепной реакции, позволяющим выявить в исследуемом биоматериале (соскобе урогенитальном, соскобе с задней стенки глотки, сперме, моче) специфические фрагменты генетического материала – ДНК Serratia species.
*Факультативные анаэробы – это микроорганизмы, процесс жизнедеятельности которых проходит без доступа кислорода, но его присутствие не является для них смертельным.
Подготовка к исследованию
Соскоб урогенитальный (цервикальный канал, влагалище, уретра)
Цервикальный канал, влагалище
Соскобы у женщин отбираются не ранее пятого дня от начала менструального цикла и не позже пятого дня до предполагаемой даты следующей менструации. Если наблюдаются явные признаки заболевания, отбор пробы проводится непосредственно в день обращения.
Требования по подготовке к тестированию:
- за день до и непосредственно в день отбора материала запрещено спринцевание влагалища;
- накануне исследования запрещено применение вагинальных препаратов – мазей, свечей и т.п.
Проба не отбирается:
- параллельно с приемом внутрь или местным применением антибиотиков – после окончания курса лечения должно пройти не менее двух недель при местной терапии и 30 дней после внутреннего приема антибактериальных препаратов;
- во время менструации;
- ранее, чем через 24-48 часов после полового контакта;
- после внутривлагалищного УЗИ;
- после колькоскопии (диагностического осмотра входа во влагалище, его стенок и шейки матки при помощи специального прибора – кольпоскопа);
- после мануального исследования и прочих манипуляций.
Мочеиспускательный канал (уретра)
У лиц обоего пола проба отбирается не ранее чем через 14 дней после применения антибиотиков местного действия и 30 дней после перорального приема противобактериальных средств.
За неделю до манипуляции рекомендуется прекратить прием всех медицинских препаратов. Если отказ от лечения невозможен, то пациенту необходимо поставить об этом в известность специалиста, направляющего его на обследование.
За 48 часов не вступать в половые контакты и не мастурбировать.
При отборе эпителиальных клеток из мочеиспускательного канала, манипуляция проводится перед мочеиспусканием или через 1,5-2 часа после него (при обильных выделениях из уретры у мужчин – через 1 час).
Соскоб клеток эпителия с задней стенки глотки
Перед отбором биологического материала необходимо учесть следующее:
- соскоб клеток, отбираемый с целью диагностики, проводится перед началом применения противобактериальных, антивирусных и противопаразитарных лекарственных средств, а также до проведения любых лечебных или диагностических мероприятий;
- отбор пробы для наблюдения за эффективностью проводимой терапии осуществляется минимум через полторы-две недели после окончания использования лекарственных средств местного действия и минимум через месяц после общего лечения.
При подготовке к взятию соскоба:
- запрещено применение препаратов для рассасывания и/или аэрозолей для орошения ротоглотки в течение 6 часов, предшествующих отбору пробы;
- запрещено использование для освежения дыхания жевательной резинки или пастилки;
- запрещено чистить зубы.
Перед проведением соскоба необходимо прополоскать рот, используя для этого воду комнатной температуры.
Для получения корректного результата тестирования все эти условия необходимо соблюсти в точности. Лечащий врач может рекомендовать иные условия проведения обследования.
Сперма
Отбор материала с целью диагностики проводится до начала противобактериального, антивирусного и противопаразитарного лечения, химиотерапии, а также до лечебных или диагностических мероприятий в месте предполагаемой локализации агента инфекции. После курса лечения проба отбирается не ранее, чем через 10-14 дней при проведении локальной терапии и через 30 дней после перорального приема антибиотиков.
Сбор спермы (эякулята) проводится посредством мастурбации в стерильный медицинский контейнер, плотно закрывающийся крышкой. Проба не отбирается в ранее использовавшиеся и вымытые или обработанные средствами дезинфекции емкости. Не рекомендуется сдавать анализ при наличии обильных гнойных выделений из мочеиспускательного канала.
После сбора материал может храниться в холодильнике при температуре +2 - +8⁰С, но не более 10-12 часов.
На анализ собирается порция первой утренней мочи, выделенной не ранее, чем через 2-3 часа после предыдущего (ночного) мочеиспускания. Ее объем должен составлять порядка 20-30 мл. Емкость, используемая для сбора биоматериала – стерильный медицинский контейнер.
Моча собирается либо до проведения химиотерапии или лечения антибиотиками, либо через месяц после окончания курса лечения.
Перед началом манипуляции необходимо тщательно обмыть гениталии. Женщинам желательно воспользоваться гигиеническим тампоном во избежание попадания в пробу слизи из влагалища. Во время менструации материал не собирается.
После наполнения контейнера на треть-половину объема, емкость с мочой плотно закрывается крышкой, дабы избежать ее вытекания.
Доставка биоматериала должна быть организована в течение максимум 6 часов. До отправки в лабораторию моча может храниться как в холодильнике (при t⁰ от +2⁰С – замораживать ее нельзя), так и в комнате, но при этом температура не должна быть выше +25⁰С.
Показания к исследованию
Тестирование предназначено для выявления в образцах биоматериала специфических фрагментов ДНК Serratia species и проводится с целью:
- определения причин развития хронического инфекционного процесса урогенитального тракта;
- диагностики заболеваний при отсутствии явных симптомов воспаления мочеполовой системы;
- диагностики бактериемии (заражения кровотока живыми бактериями);
- выявления причин образования гнойничковых поражений кожи;
- дифференцированной диагностики внутрибольничных инфекций;
- обследования лиц с ослабленным иммунитетом, наркоманов;
- оценки эффективности действия проведенного антибактериального лечения.
Интерпретация исследования
Данный тест – качественный, результат выдается в формулировках «обнаружено» или «не обнаружено».
Нормой является отсутствие в исследуемой пробе специфических фрагментов ДНК Serratia spp.
- в исследуемых образцах обнаружены специфические фрагменты ДНК Serratia spp.
- специфические фрагменты ДНК Serratia spp. не обнаружены;
- количество агента инфекции ниже порога обнаружения.
Результат анализа выдается на бланке лаборатории медицинской компании «Наука». Пример результата по данному анализу представлен ниже:
Ф.И.О.: Иванов Иван Иванович Пол: м Год рождения: 01.01.0000
Серрации. Serratia marcescens. Свойства серраций. Эпидемиология серраций. Распространенность серраций.
Серрации являются условно-патогенными микробами, вызывающими у человека гнойно-воспалительные заболевания различной локализации. Частота выделения серраций и их этиологическая роль возрастают при госпитальных инфекциях. Наличие патогенных свойств у бактерий рода Serratia обусловливает их способность вызывать инфекционный процесс. Патогенные свойства придают бактериям способность преодолевать защитные барьеры организма человека, распространяться в его тканях, подавлять неспецифическую и специфическую реактивность организма. Целью данного исследования было изучение патогенных свойств клинических штаммов бактерий рода Serratia. В данной работе было исследовано 58 клинических штаммов бактерий рода Serratia, выделенных из различного патологического материала: испражнений, мочи и гнойного отделяемого. Определяли индекс адгезивности исследованных бактерий, гемагглютинирующую способность, адсорбцию бактериями красителя конго красного. Исследовали антилизоцимную активность и гемолитическую способность. Все изученные штаммы характеризовались высоким персистентным потенциалом. Большинство изученных клинических штаммов бактерий рода Serratia обладали следующими патогенными свойствами: адгезивной, гемагглютинирующей, антилизоцимной и гемолитической активностью. Особенно сильно была выражена адгезивная активность у бактериальных культур серраций, выделенных из испражнений и гнойного отделяемого. Подавляющее большинство исследованных клинических штаммов обладало способностью агглютинировать эритроциты человека и эритроциты барана. Уровень антилизоцимной активности клинических штаммов серраций, выделенных из мочи и гнойного отделяемого, был несколько выше, чем у штаммов, выделенных из испражнений. Наиболее выраженно гемолитическая активность проявилась у штаммов серраций, выделенных из гнойного отделяемого.
1. Mahlen S.D. Serratia infections: from military experiments to current practice. Clin. Microbiol. Rev. 2011. vol. 24. no. 4. P. 755-791.
2. Bertrand X., Dowzicky M.J. Antimicrobial susceptibility among gram-negative isolates collected from intensive care units in North America, Europe, the Asia-Pacific Rim, Latin America, the Middle East, and Africa between 2004 and 2009 as part of the Tigecycline Evaluation and Surveillance Trial. Clin.Ther. 2012. vol. 34. no. 1. P. 124-137.
3. Sader H.S., Farrell D.J., Flamm R.K., Jones R.N. Antimicrobial susceptibility of Gram-negative organisms isolated from patients hospitalized in intensive care units in United States and European hospitals (2009-2011). Diagn.Microbiol Infect Dis. 2014. vol. 78. no. 4. P. 443-448.
4. Sader H.S., Castanheira M., Farrell D.J., Flamm R.K., Jones R.N. Ceftazidime-avibactam activity when tested against ceftazidime-nonsusceptible Citrobacter spp., Enterobacter spp., Serratia marcescens, and Pseudomonas aeruginosa from Unites States medical centers (2011-2014). Diagn Microbiol Infect Dis. 2015.vol.83. no. 4. P. 389-394.
6. Samonis G., Vouloumanou E.K., Christofaki M., Dimopoulou D., Maraki S., Triantafyllou E. Serratia infections in a general hospital: characteristics and outcomes. Eur. J. Clin.Microbiol. Infect Dis. 2011.vol.30. no. 5. P. 653-660.
7. Wu Y.M., Hsu P.C., Yang C.C., Chang H.J., Ye J.J., Huang C.T. Serratia marcescens meningitis: Epidemiology, prognostic factors and treatment outcomes. J. Microbiol. Immunol. Infect. 2013. vol. 46. no. 4. P. 259-265.
8. Габидуллин З.Г., Савченко Т.А., Габидуллин Ю.З., Туйгунов М.М., Булгаков А.К., Давлетшина Г.К., Суфияров Р.С., Усманова И.Н., Хуснаризанова Р.Ф. Условно-патогенные грамотрицательные и грамположительные бактерии: учебное пособие для студентов. Уфа: Издательство ГБОУ ВПО БГМУ Минздрава России. 2014. С.7-11.
9. Брилис В.И., Брилене Т.А., Ленцнер Х.П., Ленцнер А.А. Методика изучения адгезивного процесса микроорганизмов // Лабораторное дело. 1986. №4. С.210-212.
Особую значимость среди бактериальных инфекций имеют нозокомиальные заболевания [1]. С каждым годом число возбудителей внутрибольничных инфекций (ВБИ) увеличивается в основном за счет условно-патогенных микроорганизмов. Ведущую роль играют стафилококки (до 60% всех случаев ВБИ), представители грамотрицательной микрофлоры, аскомицеты рода Candida [2, 3]. Главной особенностью возбудителей внутрибольничных инфекций является их выраженная вирулентность и устойчивость к антибактериальным препаратам и дезинфектантам [4, 5]. В последние годы наряду с вышеперечисленными возбудителями ВБИ все чаще выделяются представители рода Serratia [6, 7].
Серрации – условно-патогенные микробы, вызывающие у человека гнойно-воспалительные заболевания различной локализации. Наиболее изученным видом является Serratia marcescens. В настоящее время бактерии рода Serratia marcesens описаны как возбудители диарейных заболеваний у человека, инфекций мочевыводящих путей, менингита, артрита, сепсиса [8]. Постоянный мониторинг изменяющихся биологических свойств выделенных клинических изолятов является одним из важнейших этапов эпидемиологической работы, в связи с чем актуально исследование постоянно меняющихся свойств бактерий этой группы.
Целью данного исследования было изучение патогенных свойств клинических штаммов бактерий рода Serratia.
Материал и методы исследования. В работе использовано 58 клинических штаммов, отнесенных на основании биологических свойств к роду Serratia. Штаммы Serratia были выделены из различного патологического материала: из испражнений (15 штаммов) от пациентов с кишечными инфекциями, мочи (20 штаммов) от больных с уретритами и гнойного (раневого) отделяемого (23 штамма) от пациентов с абсцессами и флегмонами мягких тканей.
Способность к адгезии у бактерий изучали с помощью формалинизированных эритроцитов человека. Определяли основные показатели адгезии. Вычислили индекс адгезивности микроорганизмов. По данному показателю все бактерии разделили на 4 группы: 1 – неадгезивные (индекс адгезивности <1,75), низкоадгезивные (индекс адгезивности 1,76–2,5), среднеадгезивные (индекс адгезивности 2,51–4,0) и высокоадгезивные (индекс адгезивности >4,0).
Адсорбцию бактериями красителя конго красного выявляли на 1,5%-ном мясопептонном агаре с добавлением 0,02% казаминовых кислот и 0,01% конго красного.
Способность к гемагглютинации у бактерий определяли в реакции гемагглютинации с 3%-ной взвесью свежих эритроцитов человека и барана, которую проводили на панелях из органического стекла.
Для выявления D-маннозорезистентной гемагглютинации во взвесь эритроцитов добавляли 1,5% D-маннозы [9].
Антилизоцимную активность изучали по методике О.В. Бухарина. Исследования антилизоцимной активности проводили в диапазоне концентраций от 1 до 6 мкг/мл. В качестве тест-культуры использовался штамм Micrococcus luteus var. Lysodeikticus № 2665. Гемолитическую способность бактерий определяли на мясопептонном агаре с 3–5% отмытых в растворе Хенкса эритроцитов кролика. Для выявления тиолзависимых гемолизинов использовался мясопептонный агар с 0,002% L-цистеина.
Статистическую обработку проводили стандартными методами.
Результаты исследования и их обсуждение
Исследование адгезивных свойств бактерий рода Serratia выявило, что адгезивные штаммы с индексом адгезивности выше 2,5 составили 70,6% (41 штамм) из общего количества изученных штаммов, из которых 13 штаммов серраций (86,7%) были выделены из испражнений, 18 штаммов серраций (78,3%) были выделены из гнойного отделяемого, 10 штаммов серраций (50%) были выделены из мочи.
Все адгезивные штаммы разделили на две группы: высокоадгезивные и со средней степенью адгезивности. К штаммам, обладающим высоким индексом адгезивности (более 4), отнесли 3 штамма серраций (20%), выделенных из испражнений, 5 штаммов серраций (21,7%), выделенных из гнойного отделяемого, все адгезивные штаммы (10 бактериальных культур), выделенные из мочи.
Сренеадгезивными оказались 23 штамма (39,7%). Индекс адгезивности у них составил от 2,5 до 4. Среди выделенных из испражнений штаммов со средним показателем ИАМ было 10 штаммов (66,7%), а выделенные из гнойного отделяемого составили 13 штаммов (56,5%). Все остальные штаммы были отнесены к низкоадгезивным с индексом адгезивности микроорганизмов от 1,76 до 2,5. 40 штаммов (68,9%) из всех изученных клинических культур серраций обладали способностью адсорбировать конго красный. Из выделенных из испражнений такой способностью обладало 14 штаммов (93,3%), 10 культур серраций, выделенных из мочи (50%), а среди выделенных из гнойного отделяемого это свойство было выявлено у 16 штаммов (69,6%) (табл. 1).
Serratia: патогенность, диагностика, симптомы, лечение и профилактика
Serratia — это представитель семейства энтеробактерий, который колонизирует слизистую оболочку респираторного, желудочно-кишечного и урогенитального трактов. В норме этот микроб не является патогеном для человека. Его болезнетворные свойства активизируются под воздействием негативных факторов. Бактерия максимально опасна для лиц с иммунодефицитом, а также для пациентов больниц, получавших длительное лечение или перенесших хирургические операции.
Серрация считается нормальным обитателем кишечника человека, обеспечивающим его адекватное функционирование. Различные эндогенные и экзогенные факторы изменяют количественное соотношение микроорганизмов в том или ином биоценозе. При этом число условных патогенов стремительно возрастает, они приобретают вирулентные свойства и становятся причиной серьезных расстройств. Чаще всего серрация поражает органы мочевыделения и дыхания, ЖКТ. У больных появляются диспепсические симптомы, нарушение стула, интоксикация, астенизация. При поражении органов мочевыделения возникают признаки дизурии, изменяются лабораторные показатели мочи. Серрация обладает гемолитическими и токсическими свойствами.
Этот условно-патогенный микроорганизм вызывает у человека различные гнойно-воспалительные заболевания:
- Мочевыделительной системы – цистит, уретрит, пиелонефрит;
- Респираторного тракта — бронхит, пневмонию;
- Среднего уха — отит;
- Органа зрения — воспаление роговицы;
- Сердца — поражение эндокарда;
- Опорно-двигательного аппарата – артрит, остеомиелит;
- Мозга — менингит.
Серрация является возбудителем нозокомиальной инфекции в реанимации и роддомах. Особенность серраций — способность к выработке ярко-красного пигмента при росте на хлебобулочных изделиях.
Первым бактерии описал микробиолог из Италии Б. Бизио. Он дал название микробам «serratia». Термин «marcescens» в переводе с латинского означает «затухающий». Такое определение бактерия получила неслучайно, а благодаря быстрому исчезновению пигмента в живом организме. Способность serratia spp к пигментообразованию первоначально послужила поводом к их изучению. Красный пигмент этих бактерий в древние времена ассоциировался с кровавыми пятнами на продуктах питания, которые тогда освящали в церкви. Их появление считалось дьявольским признаком и вызывало негодование и страх в массах.
Этиология
Serratia – прямые палочковидные бактерии, имеющие жгутики, которые обеспечивают их подвижность. Это аспорогенные хемоорганотрофные факультативно-анаэробные микроорганизмы. Все серрации продуцируют пигмент розово-красного цвета, который хорошо растворяется в воде.
Serratia marcescens под микроскопом
Тинкториальные свойства. Серрации — мелкие грамотрицательные палочки, окруженные перетрихиально расположенными жгутиками.
Serratia marcescens на агаровой пластине
Ферментативные свойства. В цветном ряду серрации расщепляют лактозу, глюкозу, инозит, глицерин. При этом выделяется кислота и газ. Дают положительную пробу с цитратом натрия и отрицательную пробу на индол, сероводород, мочевину. Серрация является оксидазоотрицательной и каталазополжительной.
Серрация обладает следующими факторами патогенности:
- Внеклеточные протеазы,
- Фимбрии,
- ДНК-аза,
- Липаза,
- Желатиназа,
- Гемолизины,
- Орнитиндекарбиксилаза,
- Термолабильный цитотоксин,
- Сидерофорная система.
Благодаря им бактерии вызывают образование гематом на коже и слизистой оболочке, развитие кератита, гемолитико-уремического синдрома и прочих патологий.
Штаммы, вызывающие острые кишечные инфекции, продуцируют энтерогемолизин, благодаря которому на средах с кровью формируются зоны просветления. Гемолитическая активность — один из основных факторов патогенности энтеробактерий, в том числе и серраций. Повреждение мембран эритроцитов и их последующее рассасывание — проявление цитотоксической активности микробов. Энтерогемолизин обусловливает развитие диареи.
Адгезивная способность серраций обусловлена ресничками, расположенными по периметру клеток. Бактерия имеет факторы персистенции, которые защищают ее от бактерицидных свойств организма и инактивируют механизмы иммунной защиты, например, систему комплемента.
Эпидемиология
Серрация обитает в объектах окружающей среды — почве, воде, на растениях, в испражнениях животных и человека. Широкая распространенность серрации марцесценс в природе обусловлена ее способностью размножаться при комнатной температуре и во влажных условиях. Бактерия обладает мультирезистентностью к антибиотикам основных групп. Она способна выживать в дезинфицирующих растворах.
Serratia marcescens — возбудитель гнойно-воспалительных, урологических, кишечных заболеваний. Эти микроорганизмы вызывают воспаление легких в экспериментальных условиях. Они поглощают железо из крови, нанося организму непоправимый вред. Описаны крупные вспышки септической инфекции и пищевой токсикоинфекции, вызванной этим микробом.
Недоношенные дети, лица с сепсисом и пациенты, перенесшие оперативные вмешательства в наибольшей степени подвержены развитию менингита, вызванного серрацией. Бактерия высевается при иммунодефиците, обусловленном ВИЧ-инфекцией, гепатитом, туберкулезом, сахарным диабетом.
Serratia marcescens — возбудитель внутрибольничных бактериемий и пневмоний, которые часто заканчиваются смертельным исходом. Бактерии вызывают воспаление мочевыводящих путей, инфицирование хирургических ран, появление гнойничков на коже. Серрациозы тесно связаны с нейрохирургическими операциями. Большое значение серраций в формировании госпитальной патологии обусловлено горизонтальной передачей инфекции через руки медицинского персонала. В организм пациентов они попадают через катетеры, трубки для интубации, дренажи, растворы для инфузионной терапии. Неоднократно были зафиксированы вспышки менингита, вызванного серрацией, в детских отделениях стационаров.
Симптоматика
Бактерии рода Serratia являются этиологическим фактором в развитии различных воспалительных процессов.
- При поражении почек и других органов мочевыделительной системы возникает пиелонефрит с бактериурией и признаками уросепсиса, цистит, уретрит. У больных на фоне общего недомогания и интоксикации появляется боль в пояснице, рези при мочеиспускание, частые позывы в туалет, дизурические расстройства. Изменяется внешний вид мочи и показатели лабораторных анализов. Моча становится мутной, содержит белок, эпителий, бактерии, кровь.
- Острые кишечные инфекции проявляются диспепсическими явлениями и лихорадкой. Симптоматика развивается быстро. Ухудшается общее состояние больных, возникает озноб и гипертермия, появляется тошнота, рвота, вздутие и урчание в животе, которые быстро сменяются режущей и схваткообразной болью. Диарейный синдром характеризуется жидким и частым стулом. В фекалиях возможно появление патологических примесей — слизи, крови. После опорожнения кишечника боль в животе на какое-то время ослабевает.
- Инфицирование респираторного тракта обычно затрагивает все отделы дыхательной системы и протекает в форме хронического воспаления бронхов, легких или эмфиземы. При локализации серрации в горле возникает асимптомная форма инфекции. В тяжелых случаях разворачивается картина острого фарингита. Возникает боль и першение в горле, появляются признаки катарального воспаления — насморк, кашель, увеличиваются регионарные лимфоузлы. Больные отказываются от еды, жалуются на ломоту во всем теле, мышечные, суставные и головную боль.
- Гнойно-септические патологии, вызванные серрацией, у больных хирургических отделений затрудняют процессы репарации и регенерации, усиливают болезнетворное воздействие истинных патогенов. Посттравматические остеомиелиты, артриты, менингиты имеют тяжелое течение и плохо поддаются противомикробной терапии.
- Эндокардит – воспаление внутренней оболочки сердца, клиническими проявлениями которого являются: лихорадка, озноб, гипергидроз по ночам, учащенное сердцебиение, одышка, бледность кожи или цианоз, упадок сил, постоянное чувство усталости, отсутствие аппетита, снижение веса, миалгия, артралгия, геморрагии на слизистых оболочках и коже.
- Бактериальный кератит — острое воспалительное заболевание роговицы, проявляющееся резкой болью в глазу, обильным выделением слезной жидкости, блефароспазмом, инъецированием глазного яблока, появлением на роговице желтых инфильтратов, серозным или гнойными отделяемым, образованием язвочек на поверхности роговицы, ухудшением зрения. Инфекционное воспаление роговой оболочки глаза быстро прогрессирует.
- В настоящее время актуальны внутрибольничные инфекции, вызываемые бактериями рода Serratia. Нозокомиальная пневмония проявляется интоксикацией, влажным или сухим кашлем, болью в груди, одышкой, хрипами, тахикардией. При бактериемии возникают ознобы, лихорадка, слабость и вялость, тошнота, признаки токсикоза и рвота.
Диагностические мероприятия
Микробиологическое исследование – выделение и идентификация Serratia marcescens из биоматериала: крови, мочи, отделяемого носоглотки, мокроты, кала, аспиратов, биоптата. Посев производят на плотные селективные питательные среды Эндо и Плоскирева, предназначенные для первичного распознавания микробов. Кровь и ликвор засевают в бульон. Изучают морфологические, культуральные и биохимические свойства выделенной культуры. Бактериоскопия окрашенного мазка позволяет определить, к какому классу микроорганизмов она относится.
Если биоматериал засевали на чашки количественным методом, то необходимо посчитать выросшие колонии, типичные для серрации. Количественная оценка 10 в 6 степени КОЕ/мл указывает на то, что именно серрация является возбудителем патологии. Меньшее значение — признак здорового бактерионосительства. Не смотря на то, что культуральный метод считается основным в диагностике бактериальных инфекций, лишь по одним результатам бактериологического исследования нельзя назначать лечение. Необходим сбор анамнеза, осмотр больного, проведение ряда дополнительных диагностических процедур.
Экспресс-метод — ПЦР-диагностика, позволяющая обнаружить ДНК серраций в исследуемом образце. С помощью ПЦР можно идентифицировать искомый участок генетического материала. Отрицательный результат анализа – ДНК серрации не обнаружена.
Общеклинические анализы и инструментальные методы являются вспомогательными. Данные гемограммы, иммунограммы, копрограммы, коагулограммы, анализа крови на биохимические маркеры позволяют правильно определить клиническую форму инфекции. Результаты рентгенологического, томографического, ультразвукового и эндоскопического исследований необходимы для проведения дифференциальной диагностики.
Лечение
Лечение заболеваний, вызванных серрациями, этиотропное. Больным на основании результатов теста на чувствительность к антибиотикам подбирают конкретные препараты с учетом индивидуальных особенностей организма. Обычно это «Амикацин», «Нетилмицин», «Рифампицин», «Полимиксин», «Меропенем», «Имипенем». Аминогликозиды часто назначают в сочетании с карбапенемами.

- Для лечения инфекции мочевыводящих путей антибиотики вводят не только парентерально и перорально. Проводят инстилляцию противомикробных средств в полость мочевого пузыря через уретру. Симптоматическая и патогенетическая терапия включают дегидратацию, дезинтоксикацию, прием жаропонижающих и противовоспалительных средств. После купирования признаков острого воспаления добавляют физиотерапевтические процедуры, которые ускоряют процесс выздоровления и восстановления утраченных функций организма.
- Острая кишечная инфекция лечится антибиотиками вместе с пре- и пробиотиками, энтеросорбентами, спазмолитиками, противодиарейными и противорвотными средствами, ферментными препаратами, солевыми растворами. Диетотерапия имеет важное значение в комплексе лечебных процедур.
- Воспаление эндокарда кроме этиотропной терапии требует проведения гипокоагуляции, которая заключается во введении гепарина с плазмой крови. Больным показан прием иммуномодуляторов и ингибиторов протеолитических ферментов. При необходимости проводится дезинтоксикационная терапия. Если медикаментозное лечение не дает положительных результатов, показано оперативное вмешательство, которое заключается в удалении очагов инфекции внутри сердца и протезировании клапанного аппарата.
- Бактериальный кератит также лечат антибактериальными средствами. Больным назначают противомикробные глазные капли «Ципролет», «Тобрекс», «Софрадекс». В тяжелых случаях инъекции антибиотиков делают в парабульбарное пространство. Местно применяют капли с антисептиками, НПВС, глюкокортикоидами. Чтобы предупредить процесс образования спаек, используют мидриатики «Мидримакс», «Ирифрин», «Цикломед». Дополнительно назначают десенсибилизирующие средства, иммуномодуляторы, поливитаминные комплексы.
- При внутрибольничной пневмонии проводят системную антибиотикотерапию, санацию дыхательных путей и дезинтоксикацию. Больным показаны дыхательные упражнения и ЛФК. Симптоматическое лечение включает прием бронхолитиков, бронходилататоров, муколитиков, отхаркивающих средств, антигистаминных и жаропонижающих препаратов.
Профилактика и прогноз
Профилактика серрациозов, как и других инфекционных заболеваний, заключается в выполнении основных правил ЗОЖ:
- Укрепление иммунитета,
- Закаливание организма,
- Соблюдение санитарных и гигиенических норм,
- Выполнение элементарных ежедневных процедур — мытье рук, умывание, гигиенический душ, расслабляющая ванна,
- Правильное питание,
- Поддержание чистоты в помещении и его регулярное проветривание,
- Регулярные занятия посильными видами спорта,
- Предупреждение стрессовых и конфликтных ситуаций, эмоциональных всплесков и нервно-психического перенапряжения,
- Отказ от табакокурения и употребления спиртных напитков,
- Полноценный сон,
- Рациональный режим труда и отдыха.
Серрация — условно-патогенный микроорганизм, обладающий всеми типичными свойствами энтеробактерий. Serratia marcescens высевается из кала как больных, так и здоровых людей, но в разном количественном соотношении. Если число микробных клеток в одном грамме кала не превышает 10 в 4 степени, говорят об отсутствии патологического процесса. Когда это количество достигает 10 в 5 или 6 степени, имеет место воспаление. Таким больным требуется этиотропная терапия.При своевременном и правильном лечении заболеваний, вызванных серрациями, прогноз на выздоровление благоприятный.
VIII Международная студенческая научная конференция Студенческий научный форум - 2016

УСТОЙЧИВОСТЬ БАКТЕРИЙ SERRATIA MARCESCENS К АНТИБИОТИКАМ
Текст работы размещён без изображений и формул.
Полная версия работы доступна во вкладке "Файлы работы" в формате PDF
В данной статье представлены исследования по антибиотикочувствительности бактерий Serratiamarcescens, выделенных из разных объектов.
Основой для формирования резистетности микроорганизмов являются мутации в их генетическом аппарате, при этом антибактериальные препараты и дезинфектанты играют роль сильнейшего селективного фактора. Следовательно, при использовании комплекса из нескольких антибиотиков или дезинфектантов будут выживать микроорганизмы, которые обладают универсальными механизмами устойчивости, направленными против большого количества антибактериальных препаратов. Селективное действие антибиотиков снижает количество только микроорганизмов чувствительных и при этом дает возможность устойчивым популяциям активно размножаться в окружающей среде [6]
Переходя к теме нашего исследования необходимо отметить, что бактерии рода Serratia(сем. Enterobacteriaceae) распространены повсеместно в окружающей среде, их выделяют из почвы, воды, воздуха, с растений, различных предметов, пищевых продуктов, а также из испражнений насекомых и грызунов [1] .
Эти микроорганизмы, особенно S.marcescens, ранее считали непатогенными и даже использовались при испытаниях аэрозолей или в исследованиях циркуляции воздуха в помещениях. Его красноватая окраска применялась в школьных экспериментах, чтобы проследить за распространением инфекции.
Цель и задачи исследования.
Целью наших исследований явилось определение антибиотикорезистентности бактерий вида Serratia marcescens выделенных из объектов окружающей среды
Материалы и методы.
Питательные среды: мясопептонный бульон, мясопептонный агар, среда КОДА, среды Эндо, Плоскирева и Левина, среды Гиса, лабораторные животные. Термостат ТС-80М-2, бактерицидная лампа, весы лабораторные, автоклав, сушильный шкаф, микроскоп МБИ-3, колбы емкостью 250 и 500 см 3 ; пипетки мерные на 1,0 см 3 ; чашки Петри, пробирки, стандарт мутности, набор красок по методу Грама.
Материалом для исследования послужили 7 штаммов бактерий вида Serratia marcescens выделенных из воды открытых водоемов (2,3) водопроводной воды централизованного хозяйственно-питьевого водоснабжения п. Октябрьский (1), песка песочниц(4,5,6) и дезраствора (7) [2,3].
Исследования проводили диско-диффузионным методом.
Для этого в стерильные чашки Петри, расположенные на горизонтальной поверхности, разливали по 20 мл мясопептонного агара. На поверхность застывшего и слегка подсушенного агара наливали 1 мл суспензии исследуемой суточной культурыSerratia marcescens, эквивалентную стандарту мутности 0,5 по Мак-Фарланду. Бактериальную взвесь равномерно распределяли по поверхности агара, а ее избыток удаляют пастеровской пипеткой. На поверхности засеянного агара пинцетом раскладывали диски с антибиотиками – по 5 – 6 дисков на каждую чашку на расстоянии 25 мм от центра чашки [1,4,5].
Для размещения дисков использовали стандартную чашку Петри диаметром 100 мм. Чашки выдерживали при 30 0 С 18 – 24 ч, после чего учитывали результаты опыта путем измерения зон задержки роста микробов вокруг дисков, включая диаметр самого диска с помощью прозрачной линейки.
Дискодиффузный метод позволил разделить нам исследуемые микроорганизмы в зависимости от диаметра зоны задержки роста на питательной среде на следующие категории:
• при зоне диаметром до 10 мм штамм расценивается как устойчивый;
• 11 – 15 мм – как малочувствительный,
• 15 – 25 мм – как чувствительный.
• Зоны, превышающие 25 мм, свидетельствуют о высокой чувствительности микроорганизма к данному антибиотику.
Результаты и выводы исследования. Результаты проведенных исследований представлены в таблице 1.
Читайте также:
